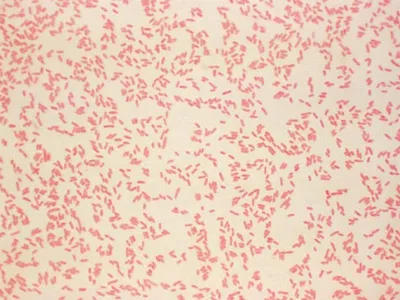

5 อันดับโรคระบาดที่พรากชีวิตคนมากที่สุดตามประวัติศาสตร์
เขียนโดย HardLife
1.โรคฝีดาษหรือไขทรพิษ (Smallpox)
ช่วงเวลา : หลายยุคหลายสมัยก่อนถึง ค.ศ. 1977
สาเหตุ : เชื้อไวรัสไวรอลา (Variola virus)
รูป : เชื้อไวรัสไวรอลา (Variola virus)
โรคฝีดาษเป็นโรคติดเชื้อร้ายแรงที่มีไข้สูงและมีผื่นตุ่มหนองทั่วร่างกาย ผู้ป่วยที่ติดเชื้อมักเสียชีวิตในอัตราสูง โดยเฉพาะในชุมชนที่ไม่มีภูมิคุ้มกันจากวัคซีน การระบาดเกิดขึ้นหลายครั้งทั่วโลกก่อนจะมีการพัฒนาวัคซีน และยังเป็นหนึ่งในโรคระบาดที่เก่าที่สุดในบันทึกประวัติศาสตร์ของมนุษย์
จำนวนผู้เสียชีวิตโดยประมาณ : 300–500 ล้านคน ตลอดประวัติศาสตร์ (เฉพาะในศตวรรษที่ 20 ก่อนการประกาศการกำจัดอย่างเป็นทางการ)
2.กาฬโรคระบาดครั้งใหญ่ (Black Death)
ช่วงเวลา : ค.ศ. 1346 – 1353
สาเหตุ : แบคทีเรีย Yersinia pestis ที่แพร่ผ่านเห็บจากหนู
รูป : แบคทีเรีย Yersinia pestis
Black Death เป็นหนึ่งในโรคระบาดครั้งใหญ่ที่สุดในยุคกลาง โดยแพร่กระจายไปทั่วทวีปยุโรป เอเชีย และแอฟริกาเหนือ ทำให้เศรษฐกิจและโครงสร้างสังคมเปลี่ยนแปลงอย่างลึกซึ้งในยุคนั้น ผู้คนจำนวนมากเสียชีวิตอย่างรวดเร็วภายในระยะเวลาไม่กี่ปี
จำนวนผู้เสียชีวิตโดยประมาณ : 75–200 ล้านคน ทั่วโลก
3.ไข้หวัดใหญ่สเปน (Spanish Flu)
รูป : Soldiers sick with Spanish flu at a hospital ward at Camp Funston in Fort Riley, Kansas
ช่วงเวลา : ค.ศ. 1918–1920
สาเหตุ : ไวรัสไข้หวัดใหญ่ชนิด A (H1N1)
รูป : ไวรัสไข้หวัดใหญ่ชนิด A (H1N1)
การระบาดใหญ่หลังสิ้นสุดสงครามโลกครั้งที่ 1 ทำให้โรคแพร่กระจายอย่างรวดเร็วทั่วโลก แม้จะใช้เวลาสั้น ๆ แต่มีอัตราการเสียชีวิตสูงโดยเฉพาะในกลุ่มคนอายุหนุ่มสาวและผู้ใหญ่สุขภาพดี ซึ่งต่างจากไข้หวัดใหญ่ทั่วไปที่มักรุนแรงในเด็กและผู้สูงอายุ
จำนวนผู้เสียชีวิตโดยประมาณ : 40–50 ล้านคน (บางแหล่งประมาณได้มากถึง 50–100 ล้าน)
4.กาฬโรคสมัยจัสติเนียน (Plague of Justinian)
ช่วงเวลา: ค.ศ. 541–542 (และอาจเกิดซ้ำเป็นระยะจนถึงราว ค.ศ.750)
สาเหตุ: แบคทีเรีย Yersinia pestis
เป็นหนึ่งในระลอกแรกของการระบาดใหญ่ของกาฬโรคในยุคโบราณ โดยเริ่มจากแอฟริกาเหนือและแพร่เข้าสู่จักรวรรดิไบแซนไทน์ รวมทั้งเมืองสำคัญหลายแห่งของยุโรปและตะวันออกกลาง แพร่เชื้ออย่างรวดเร็วผ่านเส้นทางการค้าและทหาร
จำนวนผู้เสียชีวิตโดยประมาณ : 30–50 ล้านคน
5.โรคเอดส์/HIV/AIDS Pandemic
ช่วงเวลา : ค.ศ. 1981–ปัจจุบัน
สาเหตุ : ไวรัสเอชไอวี (HIV virus)
รูป : ไวรัสเอชไอวี (HIV virus)
การติดเชื้อ HIV นำไปสู่ภาวะภูมิคุ้มกันบกพร่อง (AIDS) ซึ่งทำให้ร่างกายไม่สามารถต่อสู้กับการติดเชื้อและโรคแทรกซ้อนอื่น ๆ ได้ แม้ปัจจุบันจะมีการรักษาด้วยยาต้านไวรัสช่วยยืดอายุและลดอัตราการเสียชีวิต แต่ในช่วงหลายทศวรรษที่ผ่านมามีผู้เสียชีวิตจำนวนมากจากภาวะแทรกซ้อนของโรคนี้ทั่วโลก
จำนวนผู้เสียชีวิตโดยประมาณ : 25–35 ล้านคน (จนถึงปัจจุบัน)
อ้างอิงจาก:
1.Visualizing the History of Pandemics
2.List of natural disasters by death toll
จังหวัดเดียวในไทย ที่ ไม่มีนิคมอุตสาหกรรมเลยแม้แต่แห่งเดียว
10 จังหวัดที่ “อากาศร้อนที่สุดในไทย” ร้อนจนอยู่ยากแค่ไหน
จังหวัดไหน “ร้อนนานที่สุดในไทย” ไม่ใช่แค่ร้อนแรง แต่ร้อนยาวทั้งปี
ผู้ที่มี EQ ต่ำ มักชอบใช้ภาพพื้นหลัง 8 แบบนี้
จังหวัดเดียวในไทย ที่ไม่มีภูเขาเลยแม้แต่ลูกเดียว
10 อาชีพที่ AI กำลังแทนที่เร็วที่สุดในไทย (มีของคุณไหม)
จังหวัดที่มีโรงงานอุตสาหกรรมมากที่สุดในไทย
จังหวัดที่มีภูเขาเยอะที่สุด
ประเทศที่มีประชากรความสูงที่สุด
สิบเลขขายดีแม่จำเนียร งวด 1/4/69
ส่อง "OK ลอตเตอรี่" 10 เลขฮิตงวดวันที่ 1 เมษายน 2569
ราคาทองพุ่งไปอีกเท่าไร
โรงแรมที่มีขนาดใหญ่ที่สุด อันดับที่หนึ่งของประเทศไทย
ทายนิสัยจากไข่ดาวที่ชอบ ชอบแบบไหนบ่งบอกตัวตนที่ซ่อนอยู่ได้
จังหวัดเดียวในไทย ที่ไม่มีภูเขาเลยแม้แต่ลูกเดียว
“Affiliate Marketing” หาเงินแบบไม่ต้องมีของขายเอง!
เงินไม่พอใช้ต้องทำยังไง เปิด 5 ทางหาเงินจริง เริ่มจากศูนย์ก็มีเงินได้